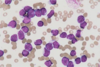

Haematological Malignancy Flashcards
(27 cards)
what is the epidemiology of haematological malignancies?
Haematological Malignancies account for approximately 11% of all human cancers (Each group of blood cancers are quite rare)
They occur in all age groups, including children (Some common cancers don’t occur in children but blood cancers do)
Adult males are more commonly affected than females
how common is haematological cancers comapred ot other cancers?

what is the incidence of Non Hodkin Lymphomain each age group?
Incidence of NHL per age group
NHL is a disease of middle and older age but can still occur in children and young adults

what is the incidence of hodgkin lymphoma in different age groups?
A different type of lymphoma
Very different age distribution
Peak incidence if between 18 and 25
Male rates are a bit higher with an exception in younger people when females are higher

what is the Pathogenesis of haematological malignancies?
Multi step (genetic) process - very complex
Acquired (Cannot pass it onto children) genetic alterations in a long lived cell - If genetic mutation in a neutrophil – doesn’t matter as it died in 6-8 hours. If mutation in stem cell then this is important as you live with it your while life
Proliferative/survival advantage to that mutated cell (Mutated cell has an advantage over the non-mutated cells)
This produces a malignant clone
The malignant clone grows to dominate the tissue (e.g bone marrow or lymph nodes)
Where does this process occur?
At the top is the multipotential haemopoietic cell – all born with a fixed amount of these cells and we keep them throughout our life’s
First important features = Can self-renew – if one divides into 2, one of the 2 daughter cells will be retained
2nd important feature = can give rise to ever cellular blood product – this is what we call multipotential

What happens to these stem cells in cancer?
Bottom left is a group of haemopoietic stem cells
Over a period of time 1 of these stem cells is genetical mutated in an important gene
Many patients we don’t know what caused this mutation
In light blue is 2 cells who have had 1 mutation, asymptomatic
With time mutation 2 occurs and this group of cells starts to grow as it has a growth advantage
Eventually the disease takes off as it has such a growth advantage it starts to dominant cells

Lineage of bone marrow malignancies - what cells make up myeloid malignancies and what cells make up lymphoid malignancies?
How we characterise these diseases:
Group into myeloid and lymphoid malignancies
Granulocyte - neutrophil

4 main groups of blood cell cancer
Subgroups of haematological malignancies - what is an Acute myeloid leukaemia?
Left is stem cells and has had a mutational event and accumulated more after the first mutational event
Acute myeloid leukaemia – these cells grow but they do not grow up, stay as immature useless cells, mutations block differentiation but allow proliferation to continue
an aggressive cancer of the myeloid cells

what is shown here?

Acute leukaemia replacing the bone marrow
Replaced with immature useless blast cells (In the myeloid cell line, the term “blast cell” refers to myeloblasts or myeloid blasts. These are the very earliest and most immature cells of the myeloid cell line)
what are Myeloproliferative disorders?
This time the mutation gives cells growth advantage and still allows them to grow up
Accumulate more end cells
Excess production of end cells
There is proliferation and maturation
These are called myeloproliferative disorders
Chronic myeloid leukaemia is the most famous one of this kind

what is shown here?
Looks very different from acute leukaemia
A few immature cells, but many mature neutrophils, eosinohpils and many platelets
This is typical of chronic myeloid leukaemia

what is acute lymphoid leukaemia?
We done myeloid malignancies, now over the the lymphoid malignancies
Still mutation in stem cells, still get proliferation but block maturation then we get acute lymphoblastic leukaemia
Acute lymphoblastic leukaemia is a type of cancer that affects white blood cells. It progresses quickly and aggressively and requires immediate treatment. Both adults and children can be affected.
cute lymphoblastic leukaemia is the most common type of leukaemia that affects children

what is shown here?
Childhood Acute Lymphoblastic Leukaemia (ALL)
Same process as acute myeloid leukaemia – proliferation without differentiation
what are Mature lymphoid malignancies?
Final group - A bit different
Mature lymphoid malignancies
Some of the diseases are caused by mutation in the stem cells and other caused by mutations in mature cells
Chronic lymphocyte leukaemia
Chronic lymphocytic leukaemia is a type of cancer that affects the white blood cells and tends to progress slowly over many years.

what is shown here?
Malignant Lymphomas
Mans is evenly distributes
Man has NHL of low grade

what is shown here?

High Grade B-cell Non-Hodgkin Lymphoma
what is a Multiple myeloma?
malignancy of plasma cells
Multiple myeloma is a cancer that forms in a type of white blood cell called a plasma cell. Healthy plasma cells help you fight infections by making antibodies that recognize and attack germs. In multiple myeloma, cancerous plasma cells accumulate in the bone marrow and crowd out healthy blood cells

what is the difference between Leukaemia v Lymphoma
Very old terms
Descriptive terms – no biological meaning
Describe the distribution of disease in the body
If disease found mainly in blood and bone marrow = leukaemia, (white blood)
If disease found mainly in lymph nodes or other organs like the liver then we called the lymphoma
These diseases can behave in either way
Tend to use the term in the way the disease most commonyl presents
The main difference between lymphocytic leukemias and lymphomas is that in leukemia, the cancer cells are mainly in the bone marrow and blood, while in lymphoma they tend to be in lymph nodes and other tissues

what is the Structure of the lymph node?
Different lymphocyte populations reside in different areas of the node – B cells in the follicles. T cells in the paracortex and plasma cells in the medulla. Within the B-cell areas different populations – Cells undergoing expansion and selection in the GCs, naive cells in the mantle zone
Medulla is where the lymphatic channels come in
Germinal centre – here is where B cells grow up

what is the process of B-cell maturation?
Released from bone marrow
Go into germinal centre of lymph node
Exposed to antigen in there that expose bits of infection and the B cells organises itself so it can recognise that antigen and can then attack it
This is a high demand process and when this goes wrong you get B cell lymphoma and this is the commonest type of lymphoma

Lymphadenopathy - what may be the cause if it is Localised and painful?
Bacterial infection in draining site e.g. otnsilar lymph nodes under the angle of the jaw when you have otnsilitis
Lymphadenopathy - what may be the cause if it is Localised and painless?
Rare infections, catch scratch fever, TB
Metastatic carcinoma from draining site- hard
Lymphoma-rubbery
Reactive, no cause identified
Lymphadenopathy - what may be the cause if it is Generalised and painful/tender?
Viral infections, EBV, CMV, hepatitis, HIV


